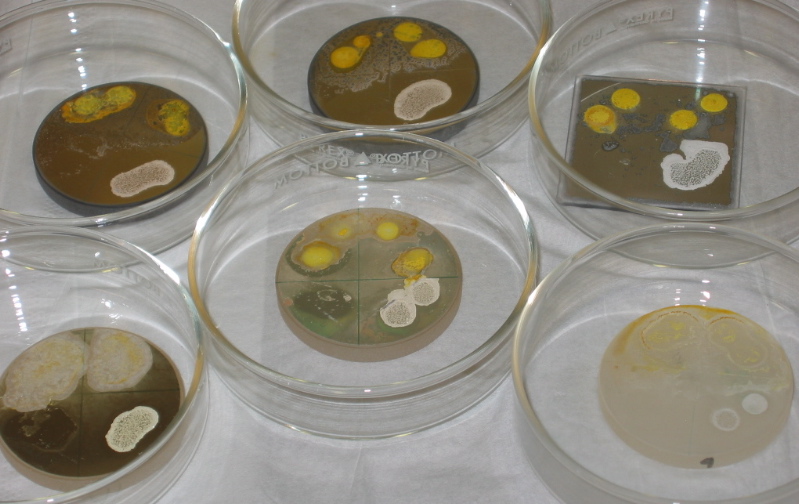
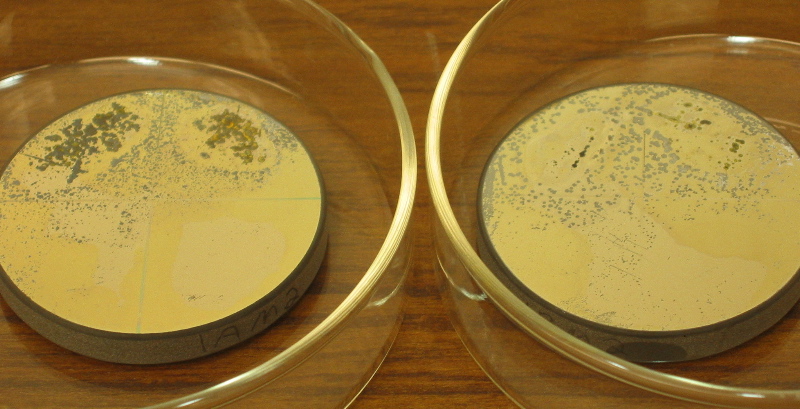
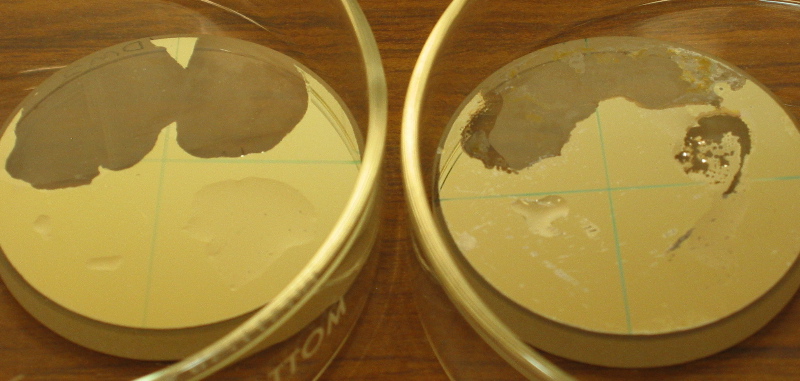
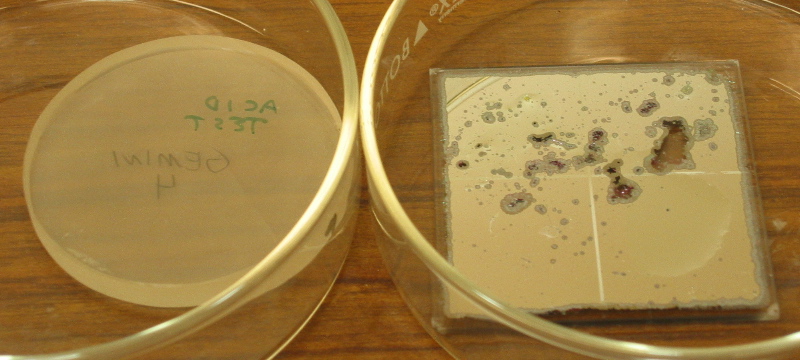

April 2005 Initial Try
We have tested 3 different chemicals in a comparison test on 6 samples of protected coatings. The test divided each sample into quarters, and two drops of each chemical was applied to a quarter of the same sample, which was then placed in a covered Petri dish overnight.The 3 chemicals were:
The 6 samples are:
Initial results are seen below:
Top row, left-to-right: PNNL-A, PNNL-B, LLNL
Bottom: PNNL-D, PNNL-E, Gemini
After washing (no rubbing):
PNNL-A, PNNL-B
PNNL-D, PNNL-E
Gemini, LLNL
Conclusions
The Ceric Sulfate + Nitric Acid appears to strip everything. Neither ammonium hydroxide nor bleach had a strong stripping effect. Obviously, some coatings (eg PNNL-B and LLNL, with the NiCrN-Ag sandwich) are harder to strip than others. The Gemini coating, as deposited, is not very robust, but PNNL-B demonstrates that the recipe itself (which is similar to the Gemini recipe) is not responsible. Thermally shocking the coating did not produce any noticible change in ease of stripping.It is interesting that the greatest damage to the coatings occurred around, rather than under, the drops of ceric sulfate solution. Therefore, our next tests will be to try nitric acid alone (without ceric sulfate) and to verify that the ceric sulfate solution alone -- rather than a combination with the ammonium hydroxide or bleach -- was responsible for the damage. Finally, we will attempt a full bath of stripping agent, rather than simply drops.
Last modified: 22apr2005
Andrew C. Phillips / Lick Observatory
phillips@ucolick.org